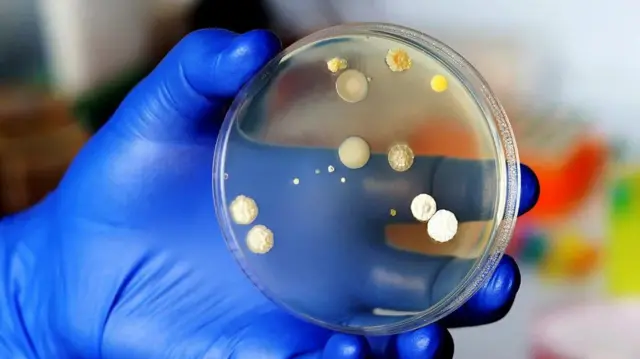
Ikiganza cyambaye udupfukantoki cyerekana udukoko twa fungi , dukunda kuba mu misego n'amashuka bifite umwanda

Wari uzi ko amashuka n'imisego turyamira bishobora kubika umwanda uruta uwo mu bwiherero?

Ahavuye isanamu, Getty Images
Abahanga bavuga ko mu buriri ari ho tumara hafi kimwe cya gatatu cy'ubuzima bwacu bwa buri munsi, kandi uko kuhatinda bituma amashuka twiyorosa n'imisego turyamira biba icumbi ry'abashyitsi badakenewe.
Nyuma y'umunsi muremure, nta kintu cyiza nko kwiryamira mu buriri buryoshye, gushyira umutwe ku musego woroshye no kwiyorosa amashuka ashyushye. Aha ariko twakubwira ko atari abantu bonyine bishimira kuryama mu buriri.
Ushobora gutungurwa no kumenya ko burya mu mashuka yawe harimo za miliyoni z'udukoko dutandukanye turimo microbe, bacteries na virusi.
Ibyo byose bifata uburiri bwawe nk'ijuru ryabyo; ahantu haba huzuye ibyuya, amacandwe, uturemangingo tw'uruhu dupfuye n'uduce tw'ibiryo bitunga turiya tunyabuzima utabonesha amaso.
Burya umuntu atakaza uturemangingo tw'uruhu tugera kuri miliyoni 500 ku munsi, kandi tukaba ari duto cyane ku buryo utatubonesha ijisho. Bityo utwo dusimba twose twaciye ingando mu buriri bwawe tuba tubonye ifunguro rihoraho.
Ikigeretse kuri ibyo rero ibisigazwa byatwo n'indi myanda ituvaho, bishobora gutera indwara z'uruhu n'iz'ubuhumekero.
Mu 2013, abashakashatsi bo mu kigo Institut Pasteur de Lille mu Bufaransa basuzumye amashuka yo ku buriri bw'abarwayi mu bitaro, basanga yuzuyemo bagiteri (bacteries) zo mu bwoko bwa Staphylococcus, bagiteri zikunze kuboneka ku ruhu rw'abantu.
N'ubwo amoko menshi ya staphylococcus atagira ingaruka mbi, amwe nka S. Aureus ashobora gutera indwara z'uruhu, ndetse n'umusonga ku bantu badafite ubudahangarwa bw'umubiri buhagije.
Manal Mohammed, umuhanga mu by'udukoko (microbiologist) muri Kaminuza ya Westminster mu Bwongereza, yagize ati:
"Abantu batwara bagiteri ku ruhu rwabo nk'igice cya microbiome y'uruhu, kandi bashobora kuzikwirakwiza ku bwinshi mu buryo bworoshye."
"Nubwo izo bagiteri akenshi zitagira ingaruka mbi, zishobora gutera indwara zikomeye iyo zinjiye mu mubiri binyuze mu bikomere bamwe mu baba baje kwivuza baba bafite."

Ahavuye isanamu, Getty Images
Ibitaro ni ahantu heza ho gukusanyirizwa amakuru menshi yifashishwa mu bushakashatsi kuko isuku yaho yitabwaho cyane, kandi amashuka n'imisego bihererekanwa buri gihe hagati y'umurwayi n'undi.
Mu 2018, abashakashatsi bo muri Kaminuza ya Ibadan muri Nigeria basanze bagiteri ya E.Coli mu mashuka yo mu bitaro yari atarameswa, hamwe n'izindi bagiteri zitera indwara zikomeye nk'izibasira imiyoboro y'inkari, umusonga, impiswi, mugiga n'indwara ya 'sepsis'.
Muri 2022, abashakashatsi bafashe ibyitegererezo mu byumba by'abarwayi bari barwaye monkeypox (ubu yitwa mpox), basanze igikorwa cyo guhindura amashuka cyaratumaga uduce twa virusi dutumuka mu kirere.
Mu 2018, umukozi wo mu rwego rw'ubuvuzi mu Bwongereza yaketsweho kuba yaranduye iyo ndwara nyuma yo guhura na virusi igihe yahinduraga amashuka yo mu buriri bw'umurwayi.
David Denning, umwarimu w'indwara zandura n'ubuzima ku isi, muri Kaminuza ya Manchester mu Bwongereza, aragira ati: "Mu bitaro, amashuka ameswa hifashishijwe amazi ashyushye cyane, agaterwa ipasi hakoreshejwe ubushyuhe buri hejuru buhagije, bigatuma bagiteri nyinshi zipfa."
Ariko hari iyihariye, ari yo C. difficile, itera impiswi, cyane cyane ku bantu bakuze. Nk'uko Denning abivuga, kumesa amashuka bishobora kwica hafi kimwe cya kabiri cya bagiteri za C. difficile, ariko amagi yayo aragorana cyane gupfa.
Ku misego n'amashuka byo mu rugo ho bite?
Mu 2013, ikigo cy'Abanyamerika gicuruza ibiryamirwa kitwa Amerisleep cyatangaje ko cyafatiye urugero ku mwenda w'umusego wari umaze icyumweru utameswa.
Basanze harimo bagiteri zigera kuri miliyoni eshatu kuri buri gice cya santimetero kare, ni ukuvuga inshuro zigera ku bihumbi 17 kurusha impuzandengo ya bagiteri ziboneka ku ntebe y'ubwiherero.
Hagati aho, mu 2006, Denning n'abandi bafatanyije na we bakusanyije imisego itandatu bayikuye ku nshuti n'abagize imiryango yabo.
Iyo misego yakoreshwaga buri gihe kandi yari imaze igihe kiri hagati y'amezi 18 n'imyaka 20 ikoreshwa.
Imisego yose yari irimo udukoko two mu bwoko bw'ibihumyo (fungi), cyane cyane ubwoko bwa Aspergillus fumigatus – ubwoko busanzwe buboneka mu butaka.
Ahavuye isanamu, Getty Images
Denning ati: "Iyo urebye ku mubare wabyo, uba uvuga za miliyari cyangwa za tiriyoni z'uduce twa 'fungus' muri buri musego."
Akomeza agira ati: "Dutekereza ko impamvu haboneka fungi nyinshi ari uko benshi muri twe tubira ibyuya mu ijoro biturutse ku mitwe yacu. Twese kandi tuba dufite udukoko duto tuva mu ivumbi riza mu nzu, iriboneka mu bitanda byacu, kandi umwanda utwo dukoko dusohora, uba ari ibiryo bibeshaho izo bagiteri.
"Hanyuma kandi, umusego ushyuha buri joro kubera ko umutwe wawe uba uryamyeho. Bityo ugira ubuhehere, maze ukorohereza za bagiteri kubona aho zitura hameze neza."
Kubera ko benshi muri twe tutamesa imisego kenshi, fungi zibamo mu buryo butabangamirana cyane kandi zishobora kubaho imyaka myinshi. Igihe cyonyine zibangamirwa ni iyo dutunganya cyangwa dukubita imisego yacu, bikaba bishobora kurekura udukoko duto twa fungus (spores) tugakwira mu cyumba turaramo cyose.
Ndetse n'iyo twayimesa, fungi zishobora kubaho ku bushyuhe bugera kuri dogere selisiyusi 50 (122°F).
Ikindi kandi, kumesha imisego bishobora kuyisigira ubuhehere bwinshi, bigatuma 'fungus' zikomeza gukura kurushaho.
Dushingiye ku gihe abantu bamara baryamye no ku kuba umusego uba hafi cyane y'umunwa, ubu bushakashatsi bwagaragaje ko ibyo bifite ingaruka zikomeye ku barwayi bafite indwara z'ubuhumekero, cyane cyane asima na sinizite.
Kugera kuri kimwe cya kabiri cy'abantu bafite asima ikabije bagira 'allergie' kuri fungi yitwa 'Aspergillus fumigatus', kandi guhura n'iyi fungus bishobora gutera indwara z'igihe kirekire z'ibihaha ku bantu bigeze kurwara igituntu cyangwa indwara z'ibihaha ziterwa no kunywa itabi.
Nk'uko Denning abivuga, n'ubwo 99.9% by'abantu bafite ubudahangarwa bw'umubiri buzima bashobora kwihanganira byoroshye guhumeka izo bagiteri, ku bantu bafite ubudahangarwa bwagabanutse, iyi fungus yabateza indwara zishobora gushyira ubuzima mu kaga.
Denning agira ati: "Niba warahawe urugingo (organ transplant), cyangwa waragize amahirwe mabi ukisanga mu byumba by'indembe bikomeye (intensive care) kubera Covid ushobora kurwara icyo bita 'invasive aspergillosis'. Icyo ni igihe fungus yinjira mu bihaha igakomeza kwiyongera igasenya utunyangingo tw'ibihaha."

Ahavuye isanamu, Getty Images
Niba kumesa imisego ntacyo bikemura, hari icyo twakora?
Nk'uko Denning abivuga, niba udafite asima, indwara z'ibihaha cyangwa izo mu mazuru, ukwiriye gutekereza ku guhindura umusego wawe buri myaka ibiri.
Ariko abantu bafite izo ndwara bo bagomba kugura umusego mushya buri mezi atatu kugeza kuri atandatu.
Hagati aho, ku bijyanye n'inshuro ugomba kumesa uburingiti n'amashuka uryamamo, abahanga benshi bajya inama yo kuyimesa buri cyumweru. Uretse kuyimesa, kuyitera ipasi nabyo bigabanya cyane umubare w'udukoko (bacteria) tuba turi ku myenda yo kuryamaho.
"Niba ufite umwanya, ushobora gutera ipasi amashuka yawe witonze, ariko twese uko byagenda kose dufite bagiteri ziva ku mubiri wacu. Gusa ku muntu ufite ubuzima bwiza, ntacyo bibangamira cyane," nk'uko Denning abivuga.
"Cyakora, niba uri umuntu urwaye kandi ubudahangarwa bwawe buri hasi, kandi niba ufite umwana urira um buriri cyangwa na we ubikora, ni ngombwa cyane kwitwararika mu kumesa no gukoresha amazi ashyushye cyane."
Ku bafite amatungo yo mu rugo nk'imbwa cyangwa injangwe, bajyana mu buriri na byo byongera umubare w'udukoko na microbe na bagiteri.
Ibi kandi biri ku kigero kimwe no kutiyuhagira mbere yo kuryama, kuryama ufite amasogisi yanduye, cyangwa kuryama ufite 'maquillage' mu maso, amavuta ku mubiri n'ibindi
Denning ati: "Simvuga ko nta wemerewe kurira mu buriri, ariko niba ubikora, ntekereza ko ugomba kumesa ibyo uryamamo kenshi gashoboka ndetse na bimwe twavugaga byo kubikora rimwe mu cyumweru byaba bidahagije. Icyi ni cyo gisubizo nyacyo numva nabaha".













